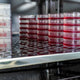

CO2Meter continues to work with many industries, leading professionals, and customers who all share the common goal in ensuring CO2 safety for their business. One specialty business we've come to know is commercial wineries and the importance of carbon dioxide in their production and bottling of wine.
Why is carbon dioxide important in wine?
Much like how beverages use carbon dioxide to make that sensational "fizz" in our favorite beverages, winemaking also relies heavily on CO2. It is during the fermentation process where the desirable end product produces a significant amount of CO2 (at times 40x the volume of the juice from the grapes).
While carbon dioxide is essential to the winemaking process there are many hazards for those working in its presence.
CO2 Safety in Winemaking
While carbon dioxide is important in the process of wine, there are also many risks when it comes to working near the gas. The major hazard is working in enclosed areas where carbon dioxide is released. This can be during any of the common processes such as pressing, wort fermentation, tank cleaning or deviating.
One of the challenges with working with CO2 is that it is a colorless, odorless and tasteless gas. Carbon dioxide is also twice as heavy as air; therefore it will sink to the bottom of a room first, creating potential deadly pools of gas that will displace oxygen. Carbon dioxide can also pose hazards as it is found to settle in corners of rooms or in areas like cellars or basements with low ventilation.
What is worse is that because you can't see, smell, or taste the gas; individuals often are not aware of its presence until unfortunate symptoms of exposure are experienced.
CO2 Hazard Levels in Wineries
Because the fermentation process produces so much carbon dioxide, unventilated areas will always pose severe concerns. Areas that are notorious for CO2 hazards in a winery include storage tanks, bottling rooms, fermentation areas, and barrel cellars.
To quantify the severity of potential CO2 exposure in wineries and beverage industries, the Occupational Safety and Health Administration (OSHA) has established Permissible Exposure Limits (PEL), Short-Term Exposure Limits (STEL), and Immediately Dangerous to Life or Health Limits (IDLH).
OSHA CO2 Concentration Levels
| 5,000 ppm | 8 hour period; Time Weighted Average (TWA) |
| 30,000 ppm | < 15 minutes; Short Term Exposure (STEL) |
| 50,000 ppm | > 5 minutes; Severe Danger to Life (IDLH) |
Note that at concentration levels above 10,000 ppm, some workers will have difficulty breathing and may experience headaches, fatigue and loss of concentration on the job.
CO2 Safety Monitoring Recommendations
- Test CO2 Levels: in all hazardous work areas or any area where employees may enter, which could have elevated levels of CO2. CO2 Safety Meters, can test for carbon dioxide and can be purchased from a variety of retailers.
- Provide CO2 Safety Training: this is critical and should always be kept up on a regular basis so employees know what to do should a CO2 leak occur.
- Prevent Confined Space Injury: always hold confined space testing of the air in accordance with a Permit-Required Confined Space Program.
Overall, successfully managing risks and safeguarding your establishment from CO2 injury is critical. For the team at CO2Meter we continue to provide industry-trusted carbon dioxide safety monitors that help protect and ensure employee safety each and very day.
CO2 Safety at Delfino Farms
To learn more about CO2 safety in a winery, we spoke with Christine Delfino Noonan, Owner/General Manager at Delfino Farms in Camino, CA.
For the past 60 years, the farms has produced some of the most recognized baked goods (Joan's Apple Bakery) hard cider and deliciously crisp wine (Edio Vineyards). They also happen to use our CO2 safety monitors to ensure establishment and employee protection.
The farm, much like others, generates an abundance of carbon dioxide during the wine production and fermentation cycle. Therefore, they are consistently aware of the importance of gas detection monitoring to further protect their staff and business.
CO2Meter: Christine, thank you for taking the time out to talk with us today. Tell us a little bit about your industry. How did you get started, and what is the main mission?
Christine Delfino Noonan: "We are in the agriculture industry with a bakery, apple orchard, vineyard, and, most recently, a winery. Our grandparents started this farm and we grew up here. We all went to Cal Poly and majored in Agriculture and the Wine Industry and came home to start our winery, Edio Vineyards."
CO2Meter: What are your field's specialty areas?
Christine Delfino Noonan: "Peter Delfino handles winemaking, Derek Delfino is in charge of vineyards, and I oversee hospitality."
CO2Meter: In your experience what has been the greatest change in your application, specifically regarding CO2?
Christine Delfino Noonan: "Overall, we think the biggest change is a more personalized experience with the creation of lighter, more delicate wines. Which we are very in favor of!"
CO2Meter: What has been the most important need or service you provide for your customers?
Christine Delfino Noonan: "The experience of tasting great wine overlooking the farm."

Pictured Above, Delfino Family at Delfino Farms
CO2Meter: Can you tell us about your experience with our CO2 Storage Safety Alarm and Personal CO2 Safety Monitor? What has been the overall need for CO2 safety monitoring in your industry?
Christine Delfino Noonan: "CO2 safety monitoring is very important in our industry. CO2 poisoning is one of the most dangerous aspects of the wine industry. We use them to keep our cellar and tasting room employees safe."
CO2Meter: Why did you choose CO2Meter as a safety provider, and utilize them for your business?
Christine Delfino Noonan: "To ensure we are being safe and keeping a safe environment for our staff."
CO2Meter: Are you concerned more about compliance, safety, or analysis regarding CO2?
Christine Delfino Noonan: "Not one area particularly, but we do try to stay up to date and ensure we are providing the safest environment."
CO2Meter: Has anyone in your company or those around you experienced any unfortunate CO2 exposure incidents?
Christine Delfino Noonan: "No."
CO2Meter: In terms of safety, how has CO2 impacted your business overall and what makes it important specifically in the winery?
Christine Delfino Noonan: "It is crucial for us providing a safe environment for our employees."
In addition to gaining industry feedback from Christine and the family at Delfino Farms, CO2Meter continues to recognize the large and continual evolving impact that carbon dioxide has continued to play in regards to the winemaking industry and many others.
Understanding the importance of CO2 safety monitoring is critical to protect and ensure safety for employees, customers and businesses like Delfino Farms.
For more information on CO2 safety in wineries, speak to an expert today: Sales@CO2Meter.com or contact us here.